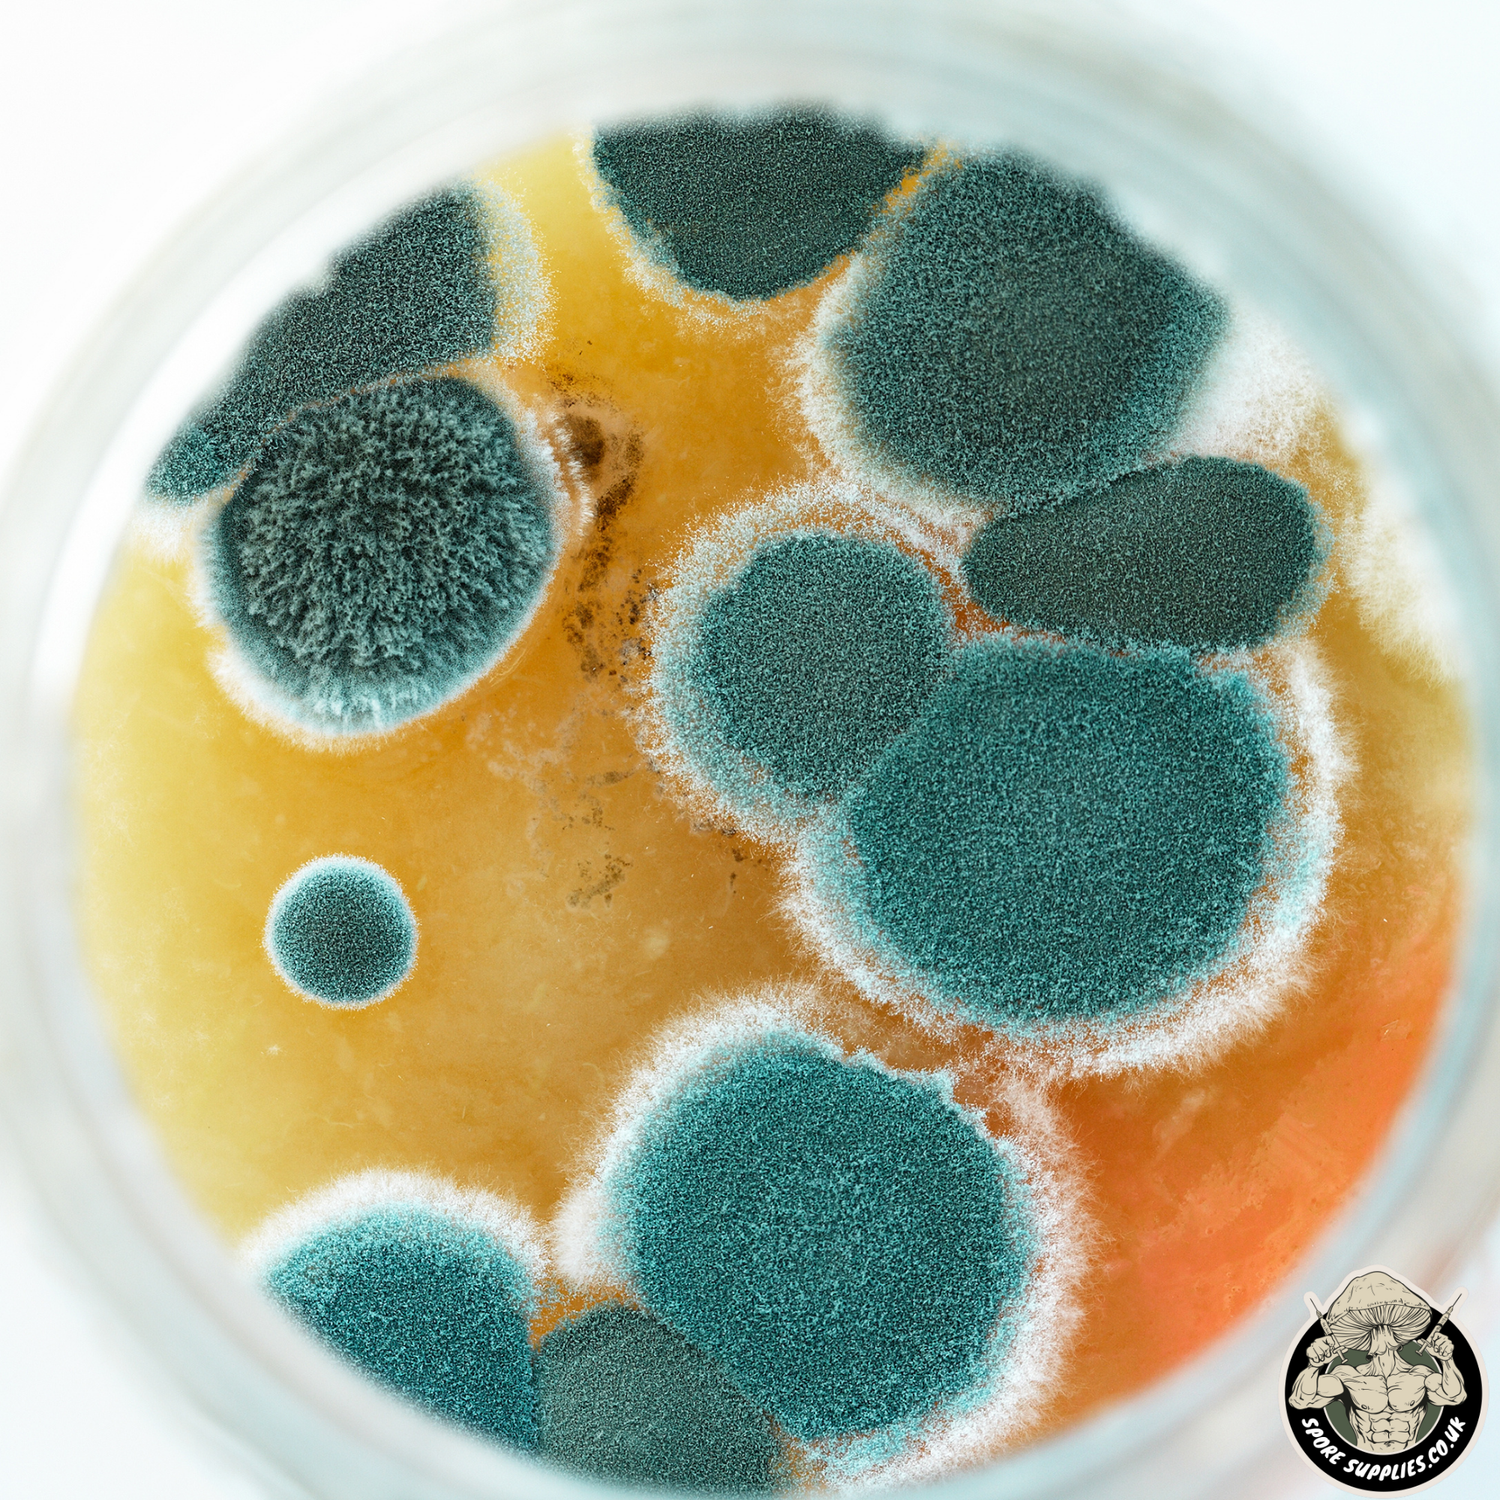
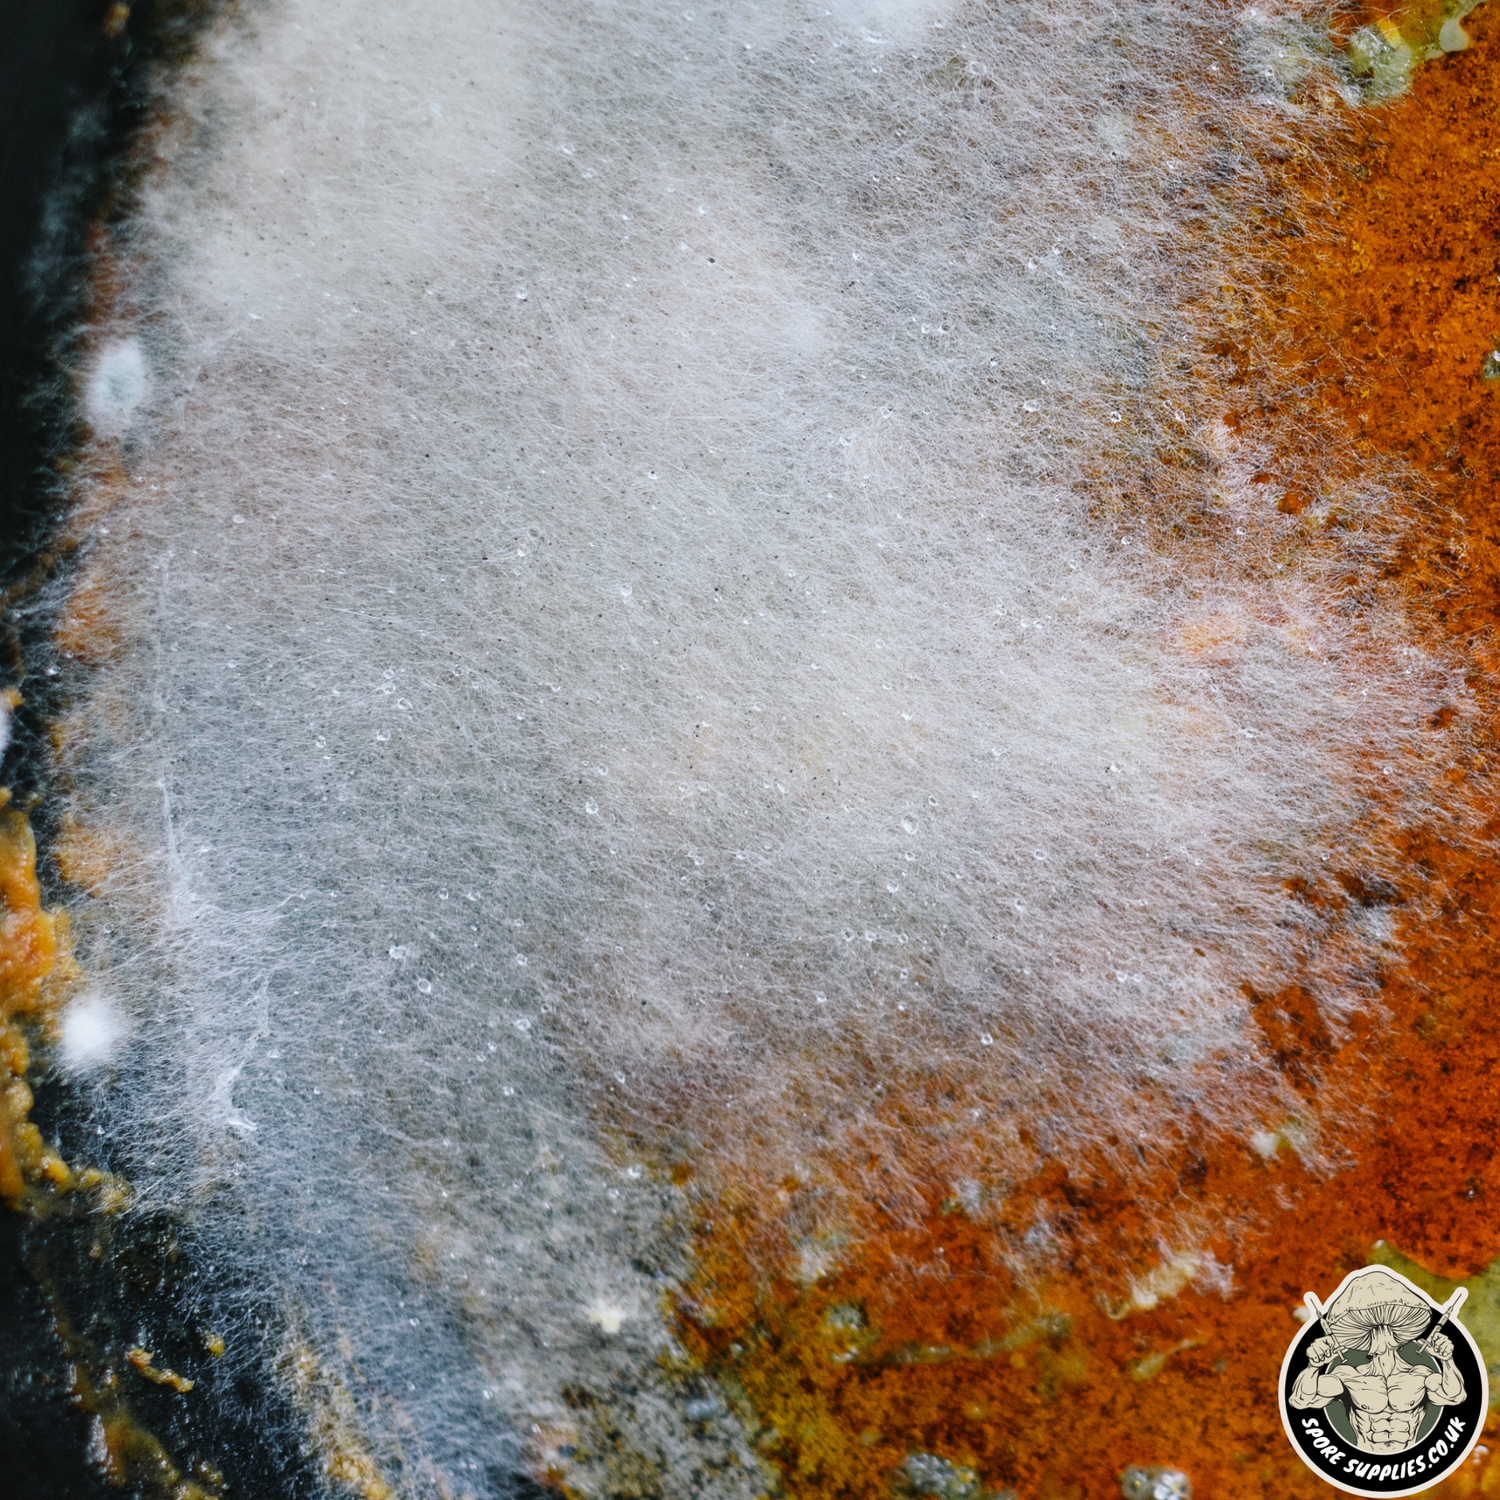

Mould or mycelium? A mushroom growers guide to contamination:
If you’re reading this, you may be wondering what contamination is, how to spot it and what you can do about it. As a mushroom grower, knowing how to deal with contamination is key. Contamination can leave your mushrooms inedible, ruining entire batches – wasting time and money in the process.
But don’t worry! In this short guide, we’ll cover the basics of contamination, so that you know what it is, how to avoid it and the difference between mycelium and mould. So, keep reading to learn all there is to know about contamination when it comes to mushroom growing!

What is contamination?
In the context of mushroom growing, contamination is any organism present in your growing medium that is not the species of fungi you intend to grow. This is usually in the form of mould or bacteria.
Different types of contamination
As mentioned above, contamination comes in many forms. Here, we’ll take a look at the most common types of contamination that mushroom growers will experience. We’ll also show you how to identify them, even the tricky ones that look similar to mycelium!
Trichoderma on Petri
1. Trichoderma
The green stuff that you won’t like when it gets angry – Trichoderma spp. This form of contamination is a green mould that is hard to miss. It starts off as a fluffy white mycelium that quickly outcompetes the species you intend to grow, before sporulating and turning green.
By far the most common source of contamination for mushroom growers, trichoderma is practically everywhere, so take precautions to make sure it doesn’t get ahold of your growing medium! If you want to take our advice, throw any growing medium that’s been contaminated with trichoderma away at the first chance you get. The risks to your health and the rest of your growing materials aren’t worth the lower yields you’ll get from any resulting flushes.

Bacillus on petri
2. Bacillus
Now here’s a tricky one! Bacillus is a bacterial contaminant that can often go undetected, but will still have an impact on your grow all the same. Bacillus is also knows as “wet spot” or “sour spot”, it has a distinct sour smell and to the naked eye, looks like a slimy, grey wet patch in your sterile grain or substrate. That’s not to say that any wet spot is Bacillus, but if a quick sniff reveals a sour smell, you likely have a clear indication that this is the culprit.
The good news is, you can actually remove Bacillus bacteria from your sterile grains by using a sterile spoon or instrument to scrape it out of the vessel its in. Your mycelium may even have a good chance of recovering and providing decent yields!
close up of cobweb mould
3. Cobweb mould
One of the hardest contaminants for new mushroom growers to identify is easily cobweb mould. This fuzzy mycelium can often look just like the mycelium you’re actually trying to cultivate and can leave you feeling proud of the rapid growth of your new project! This one has caught most of us out in our early days, but here’s a few ways to spot the difference between cobweb mould and mycelium.
The biggest tell tale that you’ve unknowingly grown cobweb mould is the smell. Instead of the mushroomy smell you can expect from healthy mycelium, cobweb mould will have a damp, musty smell – like when you’ve forgotten to hang the washing up. Aside from its distinct aroma, cobweb mould will be slightly grey in appearance and you’ll notice it quickly taking over your growing medium in just a couple days, unlike the 10-14 day period that most gourmet mushroom species take to colonise.

close up of pinhead mould
4. Pinhead mould
Pinhead mould is a fuzzy mycelium that looks similar to cobweb mould, except for the distinct black pins on the end of each mycelial thread. Like cobweb mould, it’ll quickly colonise most substrates, outcompeting the mushroom mycelium. Pinhead mould starts off as a white mycelium before turning grey and then developing black ‘pins’ – these are the spores.
It’s likely that you’ll spot pinhead mould once it has already produced spores, so your best bet is to throw away the growing medium if this is the case. These spores can be a health risk too, so go careful not to breath them in!

Next to trich on bread
5. Orange bread mould
Orange bread mould is a less common, but easy to detect mushroom contaminant. It usually contaminates substrates, especially wood based ones. You can spot orange bread mould thanks to its fast-growing orange and white mycelium. Once orange bread mould produces spores, it’ll turn bright orange and form lumps across the affected area.
This is another type of contamination that is best removed from your growing area once detected. Once the spores form, your whole growing operation could be impacted if not dealt with quickly!
what should i do if i have mushroom contamination?
Depending on the type of contamination you have, there are a few options. Any aggressive or spore producing contaminants will likely require you to dispose of the impacted grain jar, grain spawn or substrate bag.
If caught early, contamination like cobweb mould can be treated with a 3% hydrogen peroxide solution. Just dilute as needed and spray the mould to kill it off. This should give your mushroom mycelium time to recover and can allow you to still get a decent yield.
If you still fancy your chances with a contaminated bag, assuming that the contamination is not a health risk – you can always separate the affected bag or tub from your grow space – continuing to fruit it elsewhere.
how to minimise mushroom contamination:
Prevention is always better than the cure, so how can you minimise mushroom contamination? The first key is always aseptic technique. Whether you’re inoculating your agar, grains or substrate, practicing aseptic technique will minimise the risk of contamination.
aseptic technique
Buy Aseptic technique kit-

Use isopropyl
Isopropyl is like kryptonite to mould spores, so spray or wipe it wherever you think contamination could be lurking. We recommend using a 70% Isopropyl blend for best results. You can also find it inside our handy aseptic technique kit!
-

clean everything
Whether you’ve grabbed an aseptic technique kit or not, spray some isopropyl on everything you’ll be using – including surfaces, equipment and materials. Cleaning doesn’t just go for your tools! Treat yourself to a shower and a fresh set of clothes before embarking on any mycology tasks.
-

minmise airflow
There wouldn’t be any point in cleaning everything in sight if dust and mould spores could enter your environment! To increase the chances of success with growing mushrooms, minimise all sources of airborne contamination by reducing airflow – unless from a sterile source such as a HEPA filter. To minimise airflow, close windows, close doors and work in a draft-free space.
avoiding mushroom contamination when making grain & substrate
If you’re making your own sterile grain, we recommend soaking your grains for 12-24 hours before drying and sterilising them at 121 degrees for at least 2 hours and 30 minutes. This soaking period will allow would be contaminants to germinate before sterilsiation, making them vulnerable to the high temperatures of your pressure cooker or autoclave.

Leave it to us!
Or, you could just stick to the inoculations and leave the grain and substrate production to us. Grab one of our sterile grain, sterile substrate or all in one bags and minimise your chances of mushroom contamination today!



